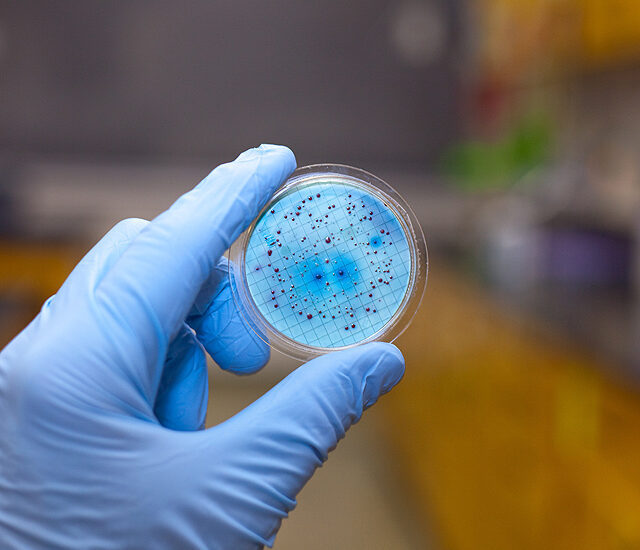
Antimicrobial-Coated Medical Devices Market

The Antimicrobial Coated Medical Devices Market plays a crucial role in preventing healthcare-associated infections (HAIs) and improving patient safety. Antimicrobial coatings are applied to medical devices to inhibit the growth of microorganisms, such as bacteria and fungi, and reduce the risk of infections associated with their use.
The need for antimicrobial-coated medical devices arises from the increasing prevalence of HAIs and the growing concern over antibiotic resistance. HAIs pose significant challenges to patient health, increase healthcare costs, and lead to prolonged hospital stays. Antimicrobial coatings provide an additional layer of protection by preventing pathogens’ colonization and biofilm formation on medical devices.
Request a Sample Copy of this research report! https://www.futuremarketinsights.com/reports/sample/rep-gb-4316
The Antimicrobial Coated Medical Devices Market is anticipated to reach US$ 1,485.0 million in 2023 and US$ 5,123.5 million by 2033. During the projection period, sales of medical devices with antimicrobial coatings are anticipated to grow significantly at a CAGR of 13.2%.
The market for antimicrobial-coated medical devices includes a wide range of products, such as catheters, implants, wound dressings, surgical instruments, and respiratory devices. These devices are utilized in various healthcare settings, including hospitals, clinics, ambulatory surgical centers, and home healthcare, to prevent infections and enhance patient outcomes.
Antimicrobial-coated catheters hold a significant share of 37.20% in the antimicrobial-coated catheters market. These catheters are designed with coatings that inhibit bacterial growth and reduce the risk of catheter-associated infections. They find application in various healthcare settings, such as hospitals and clinics. Metallic antimicrobial-coated catheters have a substantial share of 53.80% in the market. These catheters are equipped with metallic coatings, such as silver, copper, or zinc, which possess inherent antimicrobial properties.
North America dominates the antimicrobial-coated medical devices market, with a 36.2% market share. The region’s preference for advanced antimicrobial-coated medical devices and increasing government investments in medical technologies drive market growth. Europe contributes to the growth of the antimicrobial-coated medical devices market, with a 27.8% market share. The expansion of the healthcare sector in the region and the increasing demand for antimicrobial-coated medical devices propel market opportunities.
Key Takeaways Antimicrobial Coated Medical Devices Market:
- Market Growth: The antimicrobial coated medical devices market has witnessed significant growth in recent years and is expected to continue growing at a steady rate. This growth can be attributed to the increasing prevalence of hospital-acquired infections (HAIs) and the rising demand for advanced medical devices with antimicrobial properties.
- Rising Awareness about HAIs: The growing awareness about the risks associated with HAIs has led to an increased demand for antimicrobial coated medical devices. Healthcare facilities are increasingly adopting these devices to reduce the transmission of infections and improve patient safety.
- Technological Advancements: The market is driven by continuous technological advancements in the field of antimicrobial coatings. Manufacturers are investing in research and development to develop innovative coating materials that offer enhanced antimicrobial efficacy and longer-lasting protection.
- Wide Application Range: Antimicrobial coatings are used in various medical devices, including catheters, implants, surgical instruments, wound dressings, and others. The versatility of these coatings and their ability to prevent microbial colonization on the device surface make them highly desirable across different healthcare settings.
- Regulatory Guidelines: Regulatory bodies, such as the U.S. Food and Drug Administration (FDA) and the European Medicines Agency (EMA), have established guidelines and regulations for the approval and use of antimicrobial coated medical devices. Compliance with these regulations is essential for manufacturers to enter and sustain in the market.
Reach Out To Our Analyst And Get All Your Queries Answered! https://www.futuremarketinsights.com/ask-question/rep-gb-4316
Top Significant Companies in this industry comprise:
- AST products Inc.
- Covalon Technologies Ltd.
- BASF SE
- Bio Interaction Ltd.
- Royal DSM
- Sciessent LLC
- Specialty Coating Systems Inc.
- Hydromer Inc.
- Dow Chemical Company
- Biocote
- PPG Industries, Inc.
Key Market Segmentation Analysis:
The report provides insights on the important highlights and current trends prevailing in the market. This helps the readers to gain a deeper understanding and form an unbiased opinion on the market. Numerous segmentations have been provided for this market based on:
By Device Type:
- Antimicrobial Coated Catheters
- Antimicrobial Coated Surgical Instruments
- Antimicrobial Coated Implantable Devices
- Other Antimicrobial Coated Devices
By Coating Material:
- Metallic Antimicrobial Coated Medical Devices
- Silver Coating
- Copper Coating
- Other Metal Coatings
- Non-Metallic Antimicrobial Coated Medical Devices
- Polymeric Coating
- Organic Coating
By Region:
- North America
- Latin America
- The Asia Pacific
- Middle East and Africa
- Europe
Elevate Your Brand: Explore the Insights from Our Customization Report! https://www.futuremarketinsights.com/customization-available/rep-gb-4316
Important changes in market dynamics:
The report has been created after detailed and exhaustive studies by the analysts at FMI taking several factors into consideration like monetary, ecological, social, mechanical, and political status of a particular demography. They study the key data to assess the revenue and production of manufacturers across various regions. The report also covers an in-depth analysis of the key changes in market dynamics in the recent past and the near future.
Reasons to Buy the report:
- We provide authentic and detailed an analysis on various market trends to enable businesses to make informed and beneficial decisions to attain competitive edge over key players.
- Our analysts provide detailed market segmentation along with meaningful insights and extensive reports that other companies fail to include.
- The report includes accurate analysis of the market and the current developing trends affecting the growth. FMI speaks to stakeholders across the spectrum, including C-level executives, distributors, product manufacturers, industry experts. This ensures that the data collected is from highly reliable sources.
Explore FMI’s related ongoing Coverage on Healthcare Market Insights Domain:
Portable Medical Devices Market Size: https://www.futuremarketinsights.com/reports/portable-medical-devices-market
Diabetes Care Devices Market Share: https://www.futuremarketinsights.com/reports/diabetes-care-devices-market
Ultrasound Biometry Devices Market Growth: https://www.futuremarketinsights.com/reports/ultrasound-biometry-devices-market
About Future Market Insights (FMI)
Future Market Insights, Inc. (ESOMAR certified, recipient of the Stevie Award, and a member of the Greater New York Chamber of Commerce) offers profound insights into the driving factors that are boosting demand in the market. FMI stands as the leading global provider of market intelligence, advisory services, consulting, and events for the Packaging, Food and Beverage, Consumer Technology, Healthcare, Industrial, and Chemicals markets. With a vast team of over 5000 analysts worldwide, FMI provides global, regional, and local expertise on diverse domains and industry trends across more than 110 countries.
Contact Us:
Future Market Insights Inc.
Christiana Corporate, 200 Continental Drive,
Suite 401, Newark, Delaware – 19713, USA
T: +1-845-579-5705
For Sales Enquiries: sales@futuremarketinsights.com
Website: https://www.futuremarketinsights.com
LinkedIn| Twitter| Blogs | YouTube